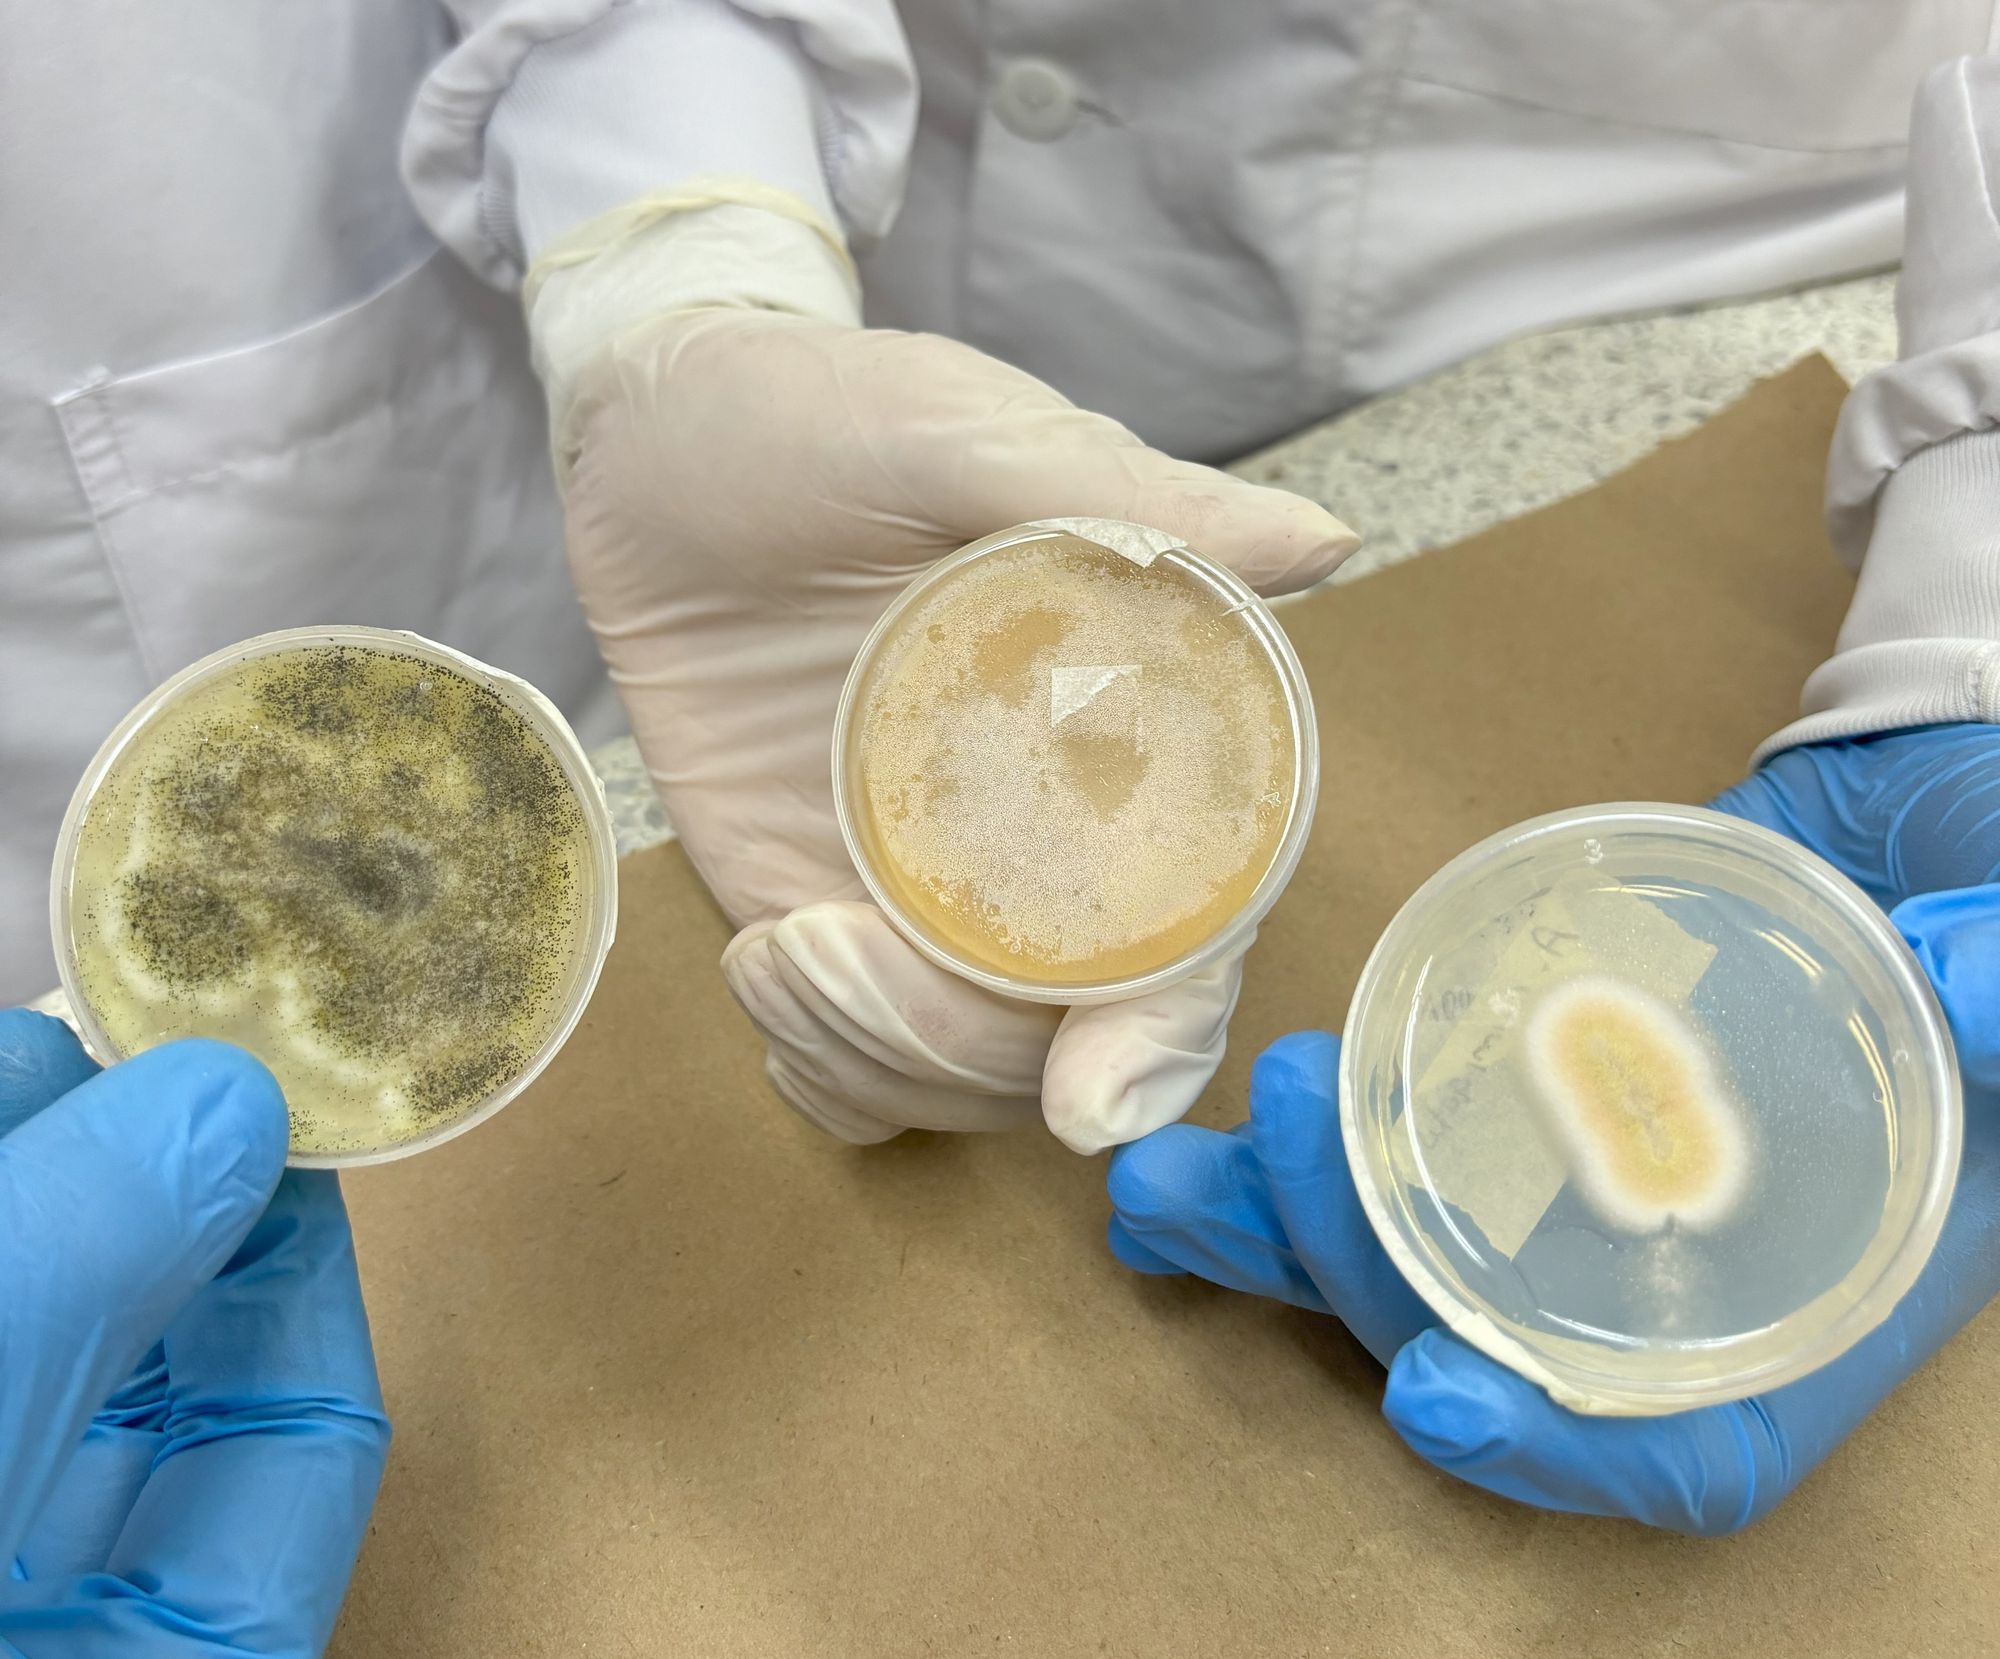
La UDES y FEDECACAO abordan el impacto de hongos en el cacao santandereano

La UDES y FEDECACAO abordan el impacto de hongos en el cacao santandereano
La Universidad de Santander (UDES), a través del Programa de Bacteriología y Laboratorio Clínico, junto con la Federación Nacional de Cacaoteros (FEDECACAO), lidera una importante iniciativa para mejorar la calidad del cacao producido en Santander, clave en la cadena productiva de chocolate y derivados. Santander es el principal productor de cacao en Colombia, con un 42% del mercado y una
Los puntos clave serán generados automáticamente por IA y revisados por la redacción de El Frente.
El contexto histórico y los antecedentes serán generados a partir del archivo periodístico de El Frente.
··········
········
La Universidad de Santander (UDES), a través del Programa de Bacteriología y Laboratorio Clínico, junto con la Federación Nacional de Cacaoteros (FEDECACAO), lidera una importante iniciativa para mejorar la calidad del cacao producido en Santander, clave en la cadena productiva de chocolate y derivados.
Santander es el principal productor de cacao en Colombia, con un 42% del mercado y una cosecha que alcanzó 28.037 toneladas en 2021. Sin embargo, el cultivo artesanal y la exposición del grano a factores ambientales hacen que el cacao sea susceptible a la contaminación por hongos. Los estudios han identificado la presencia de hongos como A. flavus y A. niger, productores de micotoxinas, compuestos que pueden afectar la salud humana e incluso ocasionar cáncer.
El objetivo de este proyecto es analizar la presencia de hongos filamentosos en todas las etapas del procesamiento del cacao, con el fin de generar mejores prácticas para los agricultores y asociaciones de la región. Además, la identificación de micotoxinas es crucial para cumplir con las normativas internacionales, lo que puede mejorar las condiciones para la comercialización del cacao y sus productos derivados.
Este estudio se convierte en una herramienta esencial para mitigar los riesgos sanitarios y aumentar la competitividad del cacao santandereano en los mercados nacionales e internacionales.





